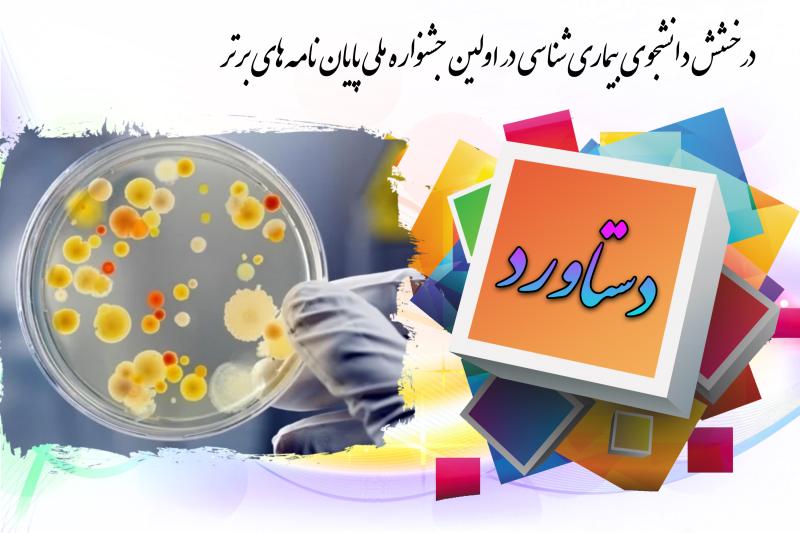

کسب عنوان "دانش آموخته شایسته تقدیر" توسط دانشآموخته بخش گیاهپزشکی دانشگاه شیراز در اولین جشنواره ملی پایان نامه برتر در علوم میکروبشناسی
در اولین جشنواره ملی پایان نامه ی برتر در علوم میکروبشناسی که در تاریخ 4 تا 6 شهریور ماه 1404 در تهران همزمان با بیست و ششمین کنگره بینالمللی میکروبشناسی ایران برگزار شد، آقای مهندس حامد نگهبان دانش آموخته ی کارشناسی ارشد بیماریشناسی گیاهی بخش گیاهپزشکی دانشکده کشاورزی دانشگاه شیراز عنوان "دانش آموخته شایسته تقدیر" را کسب کردند. پایان نامه ایشان با عنوان "دامنه ی میزبانی و ردیابی مولکولی عامل شانکر بیونکتریایی انجیر" تحت راهنمایی آقای دکتر رضا مستوفیزاده قلمفرسا استاد بخش گیاهپزشکی پیش از این، دو جایزه پایان نامه ی کارشناسی ارشد برتر سال 1403 دانشکده کشاورزی دانشگاه شیراز و پژوهشگر برتر دانشجویی دانشگاه شیراز 1403 (جایزه زنده یاد دکتر هاشم شرقی) را به خود اختصاص داده است. ایشان اکنون دانشجوی دکتری بیماری شناسی گیاهی دانشگاه شیراز هستند.